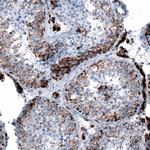
ME3 Antibody in Immunohistochemistry (IHC)

Search
Invitrogen
ME3 Polyclonal Antibody
{{$productOrderCtrl.translations['antibody.pdp.commerceCard.promotion.promotions']}}
{{$productOrderCtrl.translations['antibody.pdp.commerceCard.promotion.viewpromo']}}
{{$productOrderCtrl.translations['antibody.pdp.commerceCard.promotion.promocode']}}: {{promo.promoCode}} {{promo.promoTitle}} {{promo.promoDescription}}. {{$productOrderCtrl.translations['antibody.pdp.commerceCard.promotion.learnmore']}}
产品信息
PA5-58408
种属反应
宿主/亚型
分类
类型
抗原
偶联物
形式
浓度
规格
纯化类型
保存液
内含物
保存条件
运输条件
RRID
产品详细信息
Immunogen sequence: DVSLRIAIKV LDYAYKHNLA SYYPEPKDKE AFVRSLVYTP DYDSFTLDSY TWPKEAMNVQ TV
Highest antigen sequence identity to the following orthologs: Mouse - 87%, Rat - 76%.
靶标信息
ME3 proteins of the matrix metalloproteinase (MMP) family are involved in the breakdown of extracellular matrix in normal physiological processes, such as embryonic development, reproduction, and tissue remodeling, as well as in disease processes, such as arthritis, metastasis, and atherosclerosis. Most MMP's are secreted as inactive proproteins which are activated when cleaved by extracellular proteinases.
仅用于科研。不用于诊断过程。未经明确授权不得转售。
篇参考文献 (0)
生物信息学
蛋白别名: HME; Macrophage elastase; malate dehydrogenase (oxaloacetate-decarboxylating) (NADP(+)); Malic enzyme 3; malic enzyme 3, NADP(+)-dependent, mitochondrial; malic enzyme, NADP+-dependent, mitochondrial; ME; mitochondrial NADP(+)-dependent malic enzyme 3; MME; MMP3; NADP-dependent malic enzyme, mitochondrial; NADP-ME; pyruvic-malic carboxylase; unnamed protein product
基因别名: ME3; NADP-ME
UniProt ID: (Human) Q16798
Entrez Gene ID: (Human) 10873